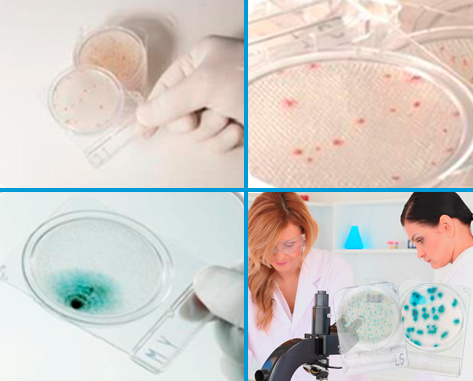

Manejo y Comodidad
- Cubierta cerrada, segura
- Sistema Parecido al tradicional
- Semejante al manejo de una caja Petri
- Empaques apilables
- Inoculación de 1.0 ml de muestra
- Inoculación directa de medios líquidos
- No requieren del uso de difusores
- Fácil de visualizar e interpretar
- Colonias con colores específicos que facilitan la interpretación
- Difusión fácil y homogénea de la muestra
- Es posible la recolección de colonias
- Menos riesgos de contaminación